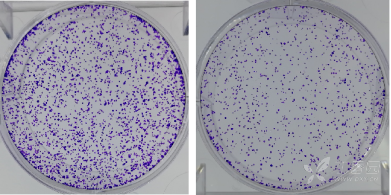
然后去固定液,加适量giemsa应用染色液染10分钟

giemsa染色法

giemsa染色法
图片尺寸750x400
cd33 sup>low /sup>cd11b sup>low /sup>髓系细
图片尺寸710x448
革兰染色原理步骤和结果意义
图片尺寸700x400
giemsa染色法
图片尺寸750x400
尿素,去垢剂或某些盐 溶预先处理,再用giemsa染料染色,称为g带
图片尺寸1080x810
图片说明:染色体核型
图片尺寸554x287
高效图片分析方法colour deconvolution除了可以用来拆分masson染色
图片尺寸1080x448
检测方法:细胞涂片或组织石蜡切片作he染色或giemsa染色,在高倍物镜下
图片尺寸581x583
然后去固定液,加适量giemsa应用染色液染10分钟
图片尺寸391x195
嗜铬细胞经过重铬酸盐的固定处理选用giemsa改良染色法能显示嗜铬胞呈
图片尺寸448x336
什么是立克次体
图片尺寸480x300
budr-giemsa显示姐妹染色单体分化染色法对人类淋巴细胞周期的初步
图片尺寸1224x1810
一,grq带技术 人类染色体用giemsa染料染色呈均质状,但是如果染色体
图片尺寸244x300
g-显带染色体核型分析图谱人 类染色体用giemsa染料染色呈均质状,但是
图片尺寸363x264
还可以用于he染色,giemsa染色,免疫组化dab染色等多种场景
图片尺寸1080x670
中国药科大学张灿团队naturenanotechnology利用免疫细胞
图片尺寸700x510
我们实验室主要采用瑞氏染色
图片尺寸1080x808
细胞学检查(tzanck涂片)以玻片在疱底作印片,wright染色或giemsa染色
图片尺寸1700x1134
实验八 牛蛙骨髓染色体标本的制备与观察2009-5ppt
图片尺寸1080x810
神经内科医生的日常@脑脊液细胞学.
图片尺寸1500x1101